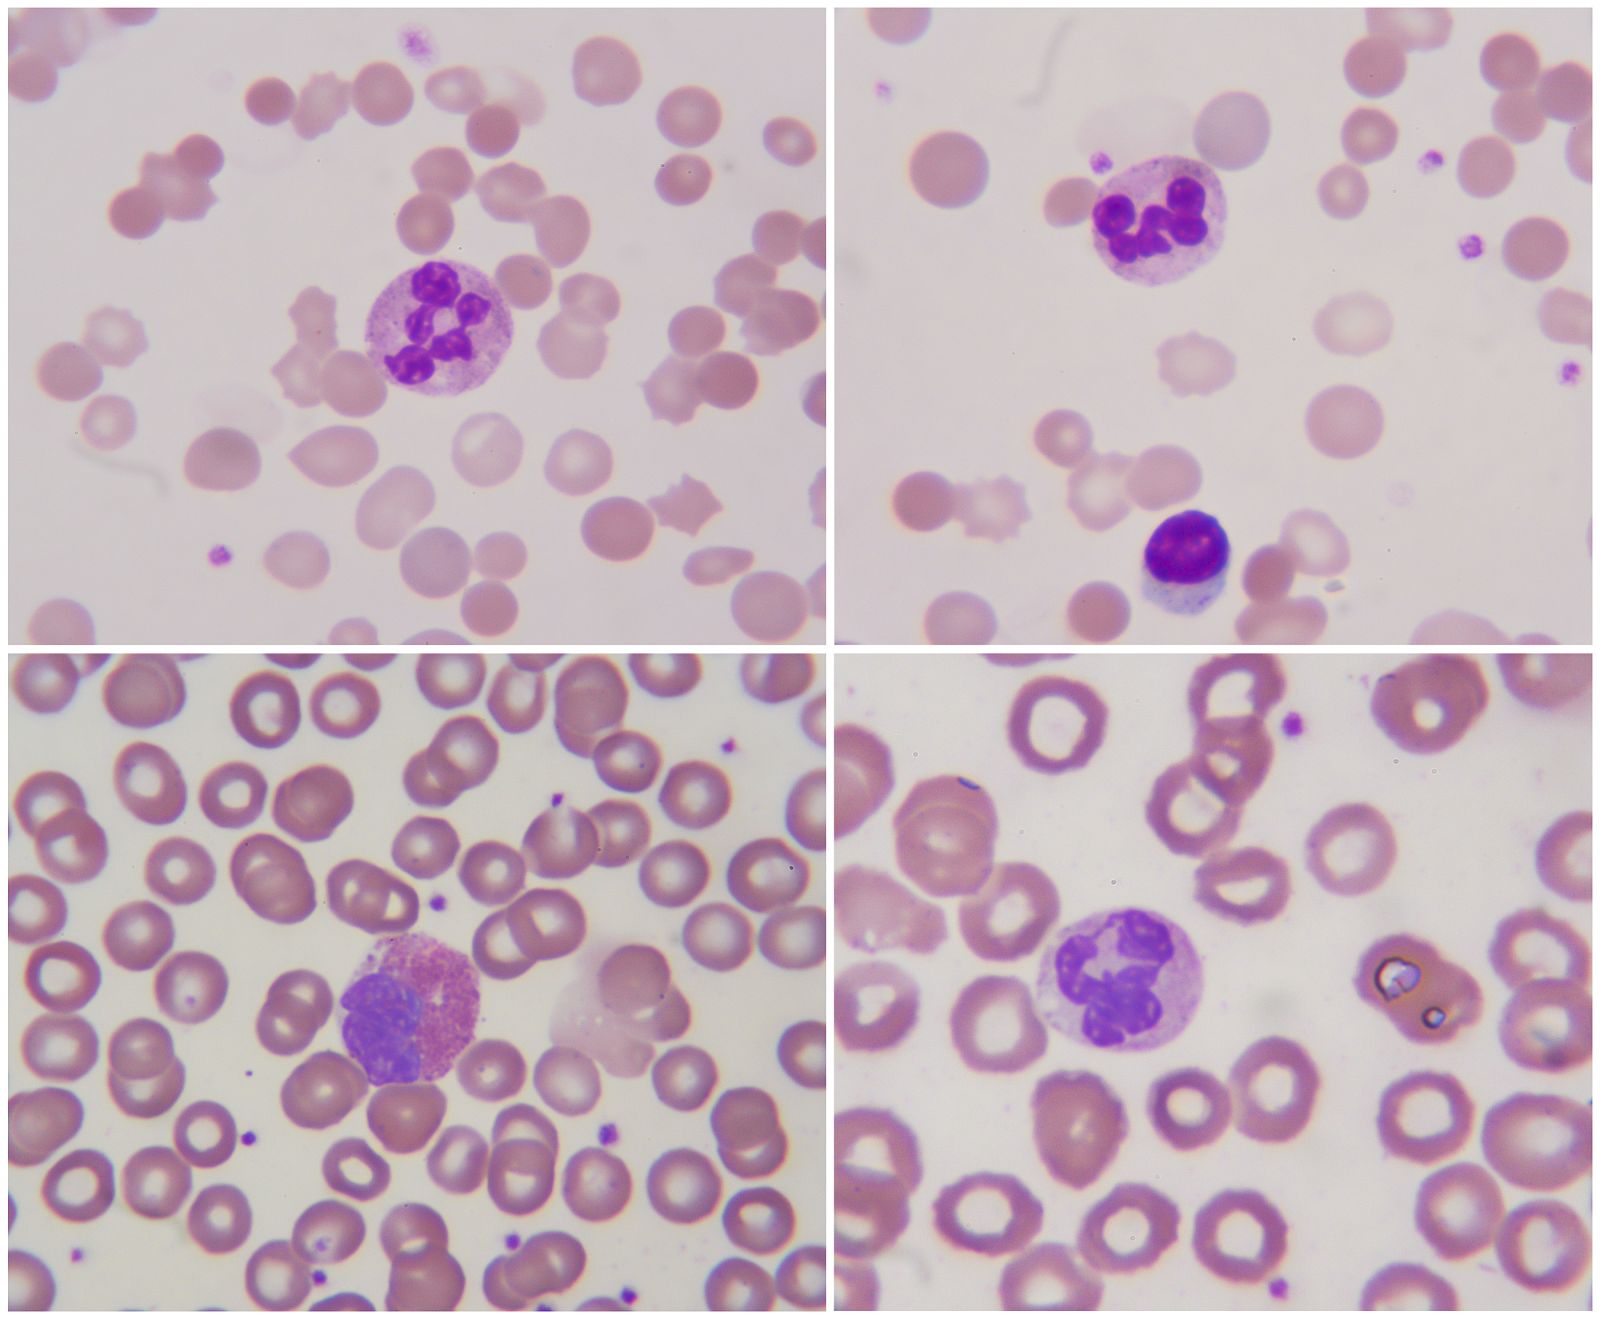
Sangre vista al microspcopio.

Crean nuevas recomendaciones para tratar la leucemia linfática crónica
- Hay dos tratamientos: trasplante de médula o nuevos fármacos
- A partir de ahora será más fácil recomendar el tratamiento adecuado
- La leucemia linfática es el 30-40% del total de leucemias

Expertos del Hospital Clínic de Barcelona han creado unas nuevas recomendaciones internacionales elegir el mejor tratamiento para los pacientes con leucemia linfática crónica (LLC) más graves.
Publicadas en la revista Blood, recoge los dos tratamientos posibles: el trasplante alogénico de médula ósea para pacientes con LLC con peor pronóstico -el único que existía hasta ahora- y la administración de nuevos fármacos.
En este último caso se trata de los inhibidores de la señal de BCR y antagonistas de BCL-2, que según los investigadores son "muy efectivos" para tratar la enfermedad, que es la forma más frecuente de este tipo de cáncer en los países occidentales y que representa un 30-40% del total de leucemias.
Ayuda para tratar a los pacientes
Estas recomendaciones, que se centran en la elección de la mejor estrategia terapéutica en cada caso, serán de gran ayuda tanto para los profesionales como para los pacientes.
Las recomendaciones recogidas en el artículo aconsejan que a todos los pacientes con LLC de alto riesgo se les ofrezca el tratamiento con los nuevos fármacos. Si responden a este tratamiento, entonces se debe plantear o bien llevar a cabo el trasplante de médula ósea o bien continuar con el tratamiento médico.
Así, a la hora de sugerir una u otra vía, se deben tener en cuenta cuáles son los riesgos que conlleva el trasplante, que son los que se analizan de forma amplia en este trabajo que sin duda significará un cambio de paradigma en el tratamiento de esta leucemia.
Leucemia linfática crónica
La LLC es la forma más frecuente de leucemia en los países occidentales y representa un 30-40% del total de leucemias. Se trata de un cáncer de un determinado tipo de glóbulos blancos, los linfocitos, y que se caracteriza por un aumento lento y progresivo de estas células en la sangre, médula ósea y otros órganos.
“Esta leucemia es un cáncer de linfocitos, un tipo de glóbulos blancos“
Su causa es desconocida y su pronóstico muy heterogéneo, de tal manera que junto a enfermos para los que la supervivencia es de tan solo unos meses, hay otros que su esperanza de vida no se ve modificada por la enfermedad. Es por ello que su tratamiento debe hacerse de acuerdo con las características del enfermo.
En la elaboración de estas recomendaciones de alcance internacional han participado dos grupos: por un lado, el Grupo Europeo para el Estudio de la LLC (European Research Initiative on CLL, ERIC), presidido por Emili Montserrat, del Servicio de Hematología del Hospital Clínic; y, por el otro, el Grupo Europeo para el Trasplante del Médula Ósea (European Society for Blood and Marrow Transplatation, EBMT), encabezado por Peter Dreger.



